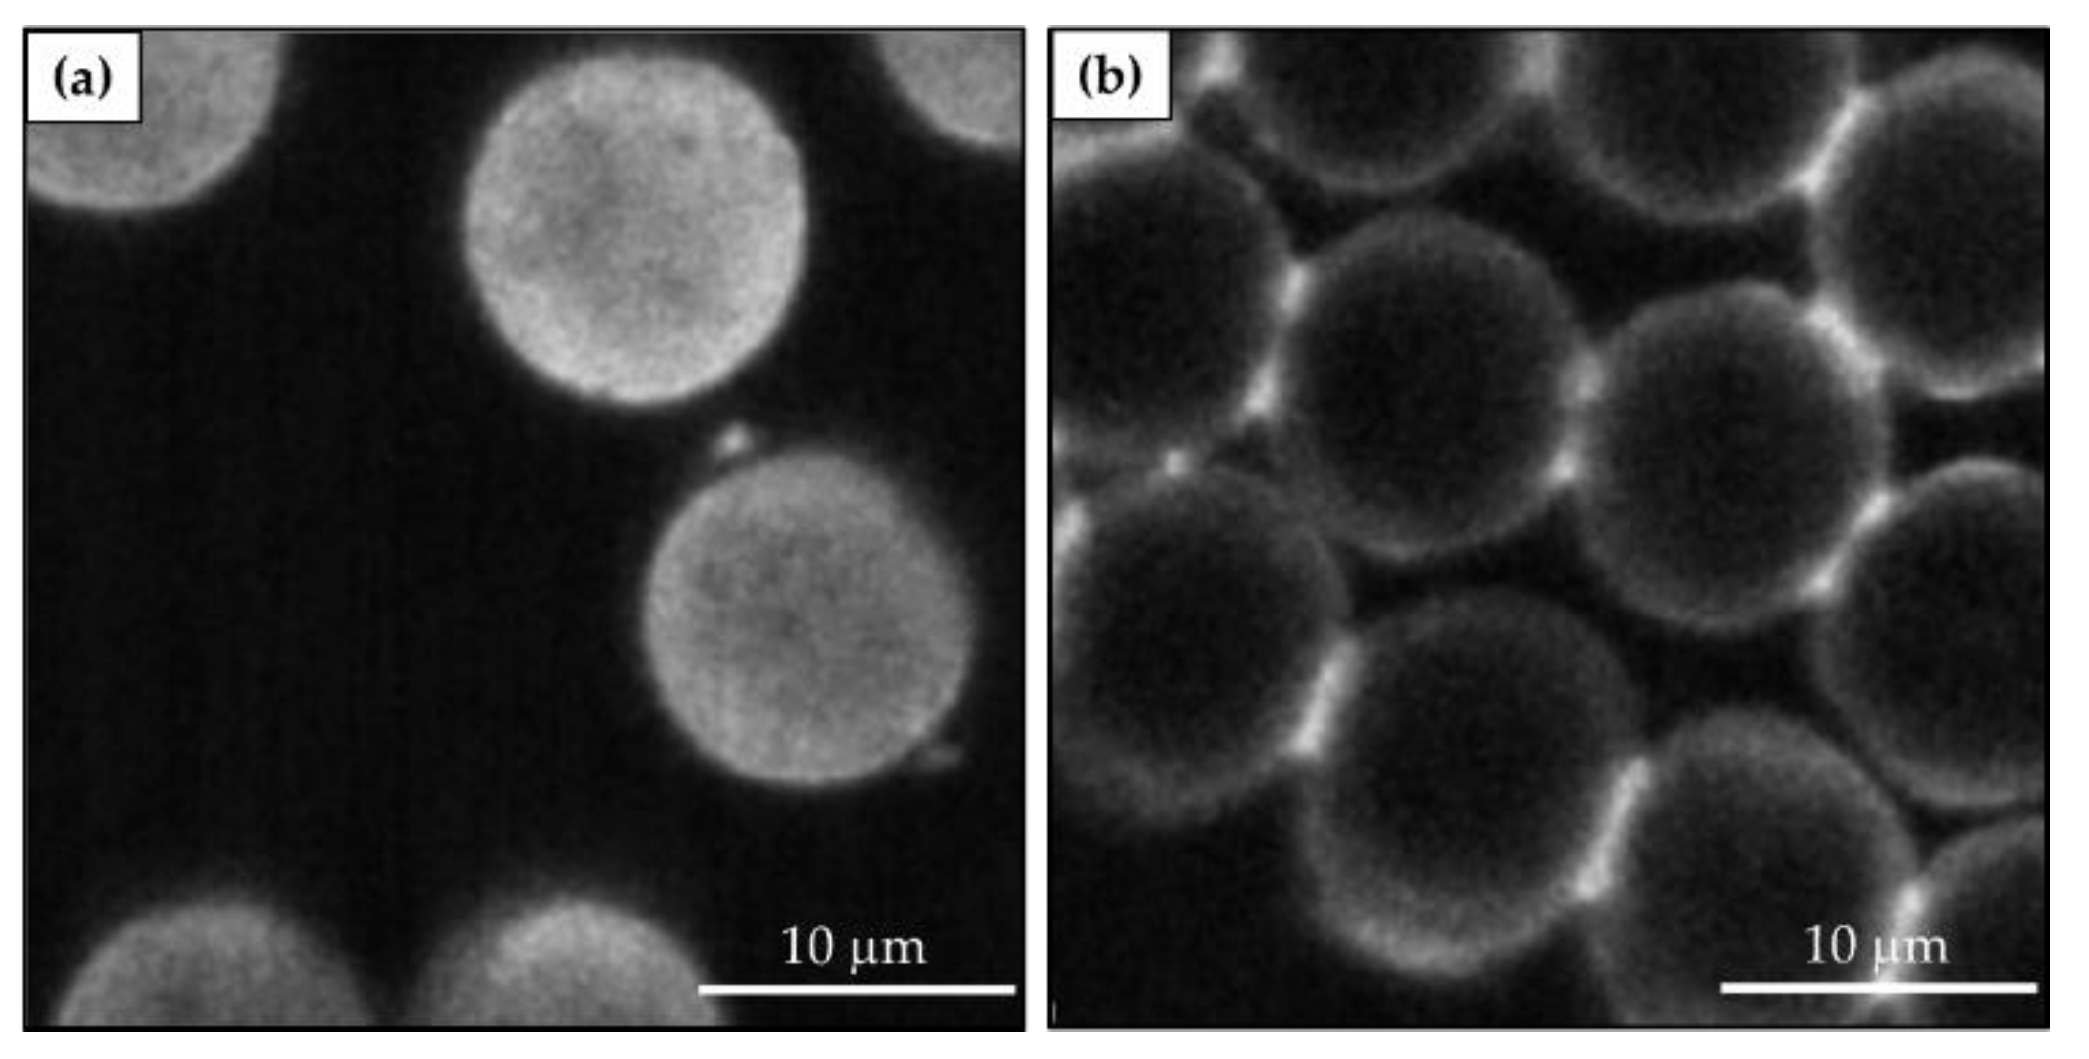

A Review of Stimuli-Responsive Smart Materials for Wearable Technology in Healthcare: Retrospective, Perspective, and Prospective
Abstract
1. Introduction
2. Flexible Electronics
3. Wearable Sensors
3.1. Chromogenic Materials
3.2. Photochromic Materials
3.3. Thermochromic Materials
- organic materials.
- inorganic and metallic compounds.
- polymeric materials.
- thin films with transition-metal oxides.
3.4. Electrochromic Materials
- cathodically coloring materials that are colorless in the oxidized state and colored in the reduced state such as WO3, MoO3, and TiO2.
- anodically coloring materials that exhibit color in the oxidized state and are colorless in the reduced state such as NiO, PB, and IrO2.
- coloring materials that are colored in both oxidized and reduced states such as V2O5, CoOx, and Rh2O3. Also, polythiophene, polypyrrole, and pyrazoline (conjugated and electro-active polymers) can exhibit electrochromic processes.
3.5. Ionochromic Materials
- halochromism owing to a change in acidic or alkaline pH;
- acidochromism stimulated by acid;
- metallochromism deriving from the formation of colored complexes from metal ions and chelating ligands.
3.6. Mechanochromic Materials
- Piezochromism, based on pressure stimuli. Piezochromic compounds are mostly prepared from conjugated polymeric materials. The color-changing property in the solid state is typical of three classes of compounds, namely, polydiacetylenes, polythiophenes, and polysilanes. Pressure and compression cause perturbations of the ground and excited states, changes in the crystal structure through first-order phase transitions, or changes in the molecular geometry in species that comprise the solid [148].
- Tribochromism, induced by friction or grinding. Tribochromic materials include spiropyran, spirooxazine, and thioindigo, and exhibit strong colored states. Besides organic compounds, some inorganic materials show mechanical color-changing properties including palladium complexes and single crystals of NaCl, CuMoO4, and LiF. However, inorganics require exposure to high pressure, in the order of thousands of MPa, to show a reaction and this is a major obstacle to their application as pressure-responsive compounds. In fact, a relatively low pressure-responsive ability is usually considered an economic factor in facilitating the application of reversible mechanochromic compounds. Occasionally, the modification of the chemical composition can enhance their performance such as substituting a small portion of Mo with W in CuMoO4. This causes the mechanical responsive capability of CuMoO4 to shift from 250 to 20 MPa [149].
3.7. Solvatochromic Materials
- Negative solvatochromism with increasing solvent polarity is regarded as a hypsochromic (or blue) shift, e.g., 4-(40-hydroxystyryl)-N-methylpyridinium iodide appears red, orange, or yellow in 1-propanol, methanol, and water, respectively.
- Positive solvatochromism with increasing solvent polarity is regarded as a bathochromic (or red) shift, e.g., 4,4′-bis(dimethylamino)fuchsone appears orange in toluene, red in acetone, and red violet in methanol.
- embedding of the chromophore in the polymer chain.
- using a solvent containing a chromophore incorporated into the polymer matrix [137].
3.8. Biochromic Materials
4. Smart Material Applications in Healthcare Technology
4.1. Applications of Halochromic Dyestuffs in Health Monitoring Sensors
4.2. Chemical Functionalization of Azo Dyestuffs for Immobilization on Textiles
4.3. Recent Examples of pH Sensor Development Based on GPTMS Dye
| Catalyst | Dyestuff | Risk | Polyamide | Cotton |
|---|---|---|---|---|
| HCl | Methyl Red![]() | Azo dye used as pH indicator and for Methyl Red test. According to the International Agency for Research on Cancer (IARC), it is classified in group 3. Moreover, it is toxic for Gambusia affinis (LC 50: 7 mg/L–96 h). The breakage of the azo bond due to biodegradation can result in the release of toxic intermetabolites [248]. | [247] | [232] [247] [243] |
| BF3OEt3 | Nitrazine Yellow![]() | pH-sensitive azo dye largely employed in cell biology, histological, and hematological stains. It is harmful and can cause life-threatening diseases and skin irritation [128]. | [240] |
4.4. Wound (pH) Sensors
5. Final Remarks and Future Perspectives
6. Conclusions
Author Contributions
Funding
Institutional Review Board Statement
Informed Consent Statement
Data Availability Statement
Acknowledgments
Conflicts of Interest
References
- Chen, S.; Qi, J.; Fan, S.; Qiao, Z.; Yeo, J.C.; Lim, C.T. Flexible Wearable Sensors for Cardiovascular Health Monitoring. Adv. Healthc. Mater. 2021, 10, 2100116. [Google Scholar] [CrossRef] [PubMed]
- Adeniyi, E.A.; Ogundokun, R.O.; Awotunde, J.B. IoMT-Based Wearable Body Sensors Network Healthcare Monitoring System. In IoT in Healthcare and Ambient Assisted Living; Marques, G., Bhoi, A.K., de Albuquerque, V.H.C., Hareesha, K.S., Eds.; Studies in Computational Intelligence; Springer: Singapore, 2021; Volume 933, pp. 103–121. ISBN 978-981-15-9897-5. [Google Scholar]
- Helbig, C.; Ueberham, M.; Becker, A.M.; Marquart, H.; Schlink, U. Wearable Sensors for Human Environmental Exposure in Urban Settings. Curr. Pollut. Rep. 2021, 7, 417–433. [Google Scholar] [CrossRef]
- Rebelo, P.; Costa-Rama, E.; Seguro, I.; Pacheco, J.G.; Nouws, H.P.A.; Cordeiro, M.N.D.S.; Delerue-Matos, C. Molecularly imprinted polymer-based electrochemical sensors for environmental analysis. Biosens. Bioelectron. 2021, 172, 112719. [Google Scholar] [CrossRef] [PubMed]
- Lee, G.; Wei, Q.; Zhu, Y. Emerging Wearable Sensors for Plant Health Monitoring. Adv. Funct. Mater. 2021, 31, 2106475. [Google Scholar] [CrossRef]
- Farrokhi, A.; Farahbakhsh, R.; Rezazadeh, J.; Minerva, R. Application of Internet of Things and artificial intelligence for smart fitness: A survey. Comput. Netw. 2021, 189, 107859. [Google Scholar] [CrossRef]
- Khoshmanesh, F.; Thurgood, P.; Pirogova, E.; Nahavandi, S.; Baratchi, S. Wearable sensors: At the frontier of personalised health monitoring, smart prosthetics and assistive technologies. Biosens. Bioelectron. 2021, 176, 112946. [Google Scholar] [CrossRef]
- Kotanen, C.N.; Moussy, F.G.; Carrara, S.; Guiseppi-Elie, A. Implantable enzyme amperometric biosensors. Biosens. Bioelectron. 2012, 35, 14–26. [Google Scholar] [CrossRef]
- Yang, Y.-L.; Chuang, M.-C.; Lou, S.-L.; Wang, J. Thick-film textile-based amperometric sensors and biosensors. Analyst 2010, 135, 1230–1234. [Google Scholar] [CrossRef]
- Yao, S.; Swetha, P.; Zhu, Y. Nanomaterial-Enabled Wearable Sensors for Healthcare. Adv. Healthc. Mater. 2018, 7, 1700889. [Google Scholar] [CrossRef]
- Pinna, G.D.; Maestri, R.; Mortara, A.; Johnson, P.; Andrews, D.; Ponikowski, P.; Witkowski, T.; La Rovere, M.T.; Sleight, P. Long-term time-course of nocturnal breathing disorders in heart failure patients. Eur. Respir. J. 2010, 35, 361–367. [Google Scholar] [CrossRef]
- Ledet, E.H.; D’Lima, D.; Westerhoff, P.; Szivek, J.A.; Wachs, R.A.; Bergmann, G. Implantable sensor technology: From research to clinical practice. J. Am. Acad. Orthop. Surg. 2012, 20, 383–392. [Google Scholar] [CrossRef] [PubMed]
- Deng, Z.-S.; Liu, J. Effect of fixing material on skin-contact temperature measurement by wearable sensor. In Proceedings of the 2008 5th International Summer School and Symposium on Medical Devices and Biosensors, Hong Kong, China, 1–3 June 2008; pp. 137–140. [Google Scholar]
- Fu, X.; Chen, W.; Ye, S.; Tu, Y.; Tang, Y.; Li, D.; Chen, H.; Jiang, K. A Wireless Implantable Sensor Network System for In Vivo Monitoring of Physiological Signals. IEEE Trans. Inf. Technol. Biomed. 2011, 15, 577–584. [Google Scholar] [PubMed]
- Kassal, P.; Steinberg, M.D.; Steinberg, I.M. Wireless chemical sensors and biosensors: A review. Sens. Actuators B Chem. 2018, 266, 228–245. [Google Scholar] [CrossRef]
- Lam Po Tang, S.; Stylios, G.K. An overview of smart technologies for clothing design and engineering. Int. J. Cloth. Sci. Technol. 2006, 18, 108–128. [Google Scholar] [CrossRef]
- Tröster, G. The Agenda of Wearable Healthcare. IMIA Yearb. Med. Inform. 2005, 14, 125–138. [Google Scholar] [CrossRef]
- Kim, J.; Campbell, A.S.; de Ávila, B.E.-F.; Wang, J. Wearable biosensors for healthcare monitoring. Nat. Biotechnol. 2019, 37, 389–406. [Google Scholar] [CrossRef]
- Aziz, O.; Atallah, L.; Lo, B.; Elhelw, M.; Wang, L.; Yang, G.Z.; Darzi, A. A pervasive body sensor network for measuring postoperative recovery at home. Surg. Innov. 2007, 14, 83–90. [Google Scholar] [CrossRef]
- Mathie, M.J.; Coster, A.C.; Lovell, N.H.; Celler, B.G.; Lord, S.R.; Tiedemann, A. A pilot study of long-term monitoring of human movements in the home using accelerometry. J. Telemed. Telecare 2004, 10, 144–151. [Google Scholar] [CrossRef]
- Giansanti, D.; Maccioni, G.; Morelli, S. An experience of health technology assessment in new models of care for subjects with Parkinson’s disease by means of a new wearable device. Telemed. J. E Health 2008, 14, 467–472. [Google Scholar] [CrossRef]
- Sazonov, E.S.; Fulk, G.; Sazonova, N.; Schuckers, S. Automatic recognition of postures and activities in stroke patients. Conf. Proc. IEEE Eng. Med. Biol. Soc. 2009, 2009, 2200–2203. [Google Scholar]
- Amft, O.; Troster, G. Recognition of dietary activity events using on-body sensors. Artif. Intell. Med. 2008, 42, 121–136. [Google Scholar] [CrossRef] [PubMed]
- Benedetti, M.G.; Di Gioia, A.; Conti, L.; Berti, L.; Esposti, L.D.; Tarrini, G.; Melchionda, N.; Giannini, S. Physical activity monitoring in obese people in the real life environment. J. Neuroeng. Rehabil. 2009, 6, 47. [Google Scholar] [CrossRef] [PubMed]
- Merilahti, J.; Pärkkä, J.; Antila, K.; Paavilainen, P.; Mattila, E.; Malm, E.J.; Saarinen, A.; Korhonen, I. Compliance and technical feasibility of long-term health monitoring with wearable and ambient technologies. J. Telemed. Telecare 2009, 15, 302–309. [Google Scholar] [CrossRef]
- Sung, M.; Marci, C.; Pentland, A. Wearable feedback systems for rehabilitation. J. Neuroeng. Rehabil. 2005, 2, 17. [Google Scholar] [CrossRef]
- Mundt, C.W.; Montgomery, K.N.; Udoh, U.E.; Barker, V.N.; Thonier, G.C.; Tellier, A.M.; Ricks, R.D.; Darling, R.B.; Cagle, Y.D.; Cabrol, N.A.; et al. A multiparameter wearable physiologic monitoring system for space and terrestrial applications. IEEE Trans. Inf. Technol. Biomed. 2005, 9, 382–391. [Google Scholar] [CrossRef] [PubMed]
- Chiarelli, A.M.; Libertino, S.; Zappasodi, F.; Mazzillo, M.; Di Pompeo, F.; Merla, A.; Lombardo, S.; Fallica, G. Characterization of a fiberless, multichannel optical probe for continuous-wave functional near-infrared spectroscopy based on silicon photomultipliers detectors: In-vivo assessment of primary sensorimotor response. Neurophotonics 2017, 4, 035002. [Google Scholar] [CrossRef]
- Maira, G.; Chiarelli, A.M.; Brafa, S.; Libertino, S.; Fallica, G.; Merla, A.; Lombardo, S. Imaging System Based on Silicon Photomultipliers and Light Emitting Diodes for Functional Near-Infrared Spectroscopy. Appl. Sci. 2020, 10, 1068. [Google Scholar] [CrossRef]
- Lombardo, S.A.; Maira, G.A.; Libertino, S.; Merla, A.; Chiarelli, A.M. Circuit, Procedure, and Algorithm to Operate SiPM Photodetectors in Optimal Conditions for fNIRS / DOT Systems. Italian Patent n. 10201900016424, 16 September 2019. [Google Scholar]
- Anliker, U.; Ward, J.A.; Lukowicz, P.; Troster, G.; Dolveck, F.; Baer, M.; Keita, F.; Schenker, E.B.; Catarsi, F.; Coluccini, L.; et al. AMON: A wearable multiparameter medical monitoring and alert system. IEEE Trans. Inf. Technol. Biomed. 2004, 8, 415–427. [Google Scholar] [CrossRef]
- Patel, S.; Park, H.; Bonato, P.; Chan, L.; Rodgers, M. A Review of Wearable Sensors and Systems with Application in Rehabilitation. J. Neuro Eng. Rehabil. 2012, 9, 21. [Google Scholar] [CrossRef]
- Park, Y.K.; Oh, H.J.; Bae, J.H.; Lim, J.Y.; Lee, H.D.; Hong, S.I.; Son, H.S.; Kim, J.H.; Lim, S.J.; Lee, W. Colorimetric Textile Sensor for the Simultaneous Detection of NH3 and HCl Gases. Polymers 2020, 12, 2595. [Google Scholar] [CrossRef]
- Van der Schueren, L.; De Clerck, K. Coloration and application of pH-sensitive dyes on textile materials. Color. Technol. 2012, 128, 82–90. [Google Scholar] [CrossRef]
- Owyeung, R.E.; Panzer, M.J.; Sonkusale, S.R. Colorimetric gas sensing washable threads for smart textiles. Sci. Rep. 2019, 9, 5607. [Google Scholar] [CrossRef]
- Schoolaert, E.; Hoogenboom, R.; De Clerck, K. Colorimetric nanofibers as optical sensors. Adv. Funct. Mater. 2017, 27, 1702646. [Google Scholar] [CrossRef]
- Qin, M.; Guo, H.; Dai, Z.; Yam, X.; Ning, X. Advances in flexible and wearable pH sensors for wound healing monitoring. J. Semicond. 2019, 40, 111607. [Google Scholar] [CrossRef]
- Kim, S.H.; Bae, J.S. Halochromic chemosensor prepared by pyran-based nanofibers. Fibers Polym. 2013, 14, 1981–1984. [Google Scholar] [CrossRef]
- Dargaville, T.R.; Farrugia, B.L.; Broadbent, J.A.; Pace, S.; Upton, Z.; Voelcker, N.H. Sensors and imaging for wound healing: A review. Biosens. Bioelectron. 2013, 41, 30–42. [Google Scholar] [CrossRef]
- Agarwal, A.; Raheja, A.; Natarajan, T.S.; Chandra, T.S. Development of universal pH sensing electrospun nanofibers. Sens. Actuators B Chem. 2012, 161, 1097–1101. [Google Scholar] [CrossRef]
- Pakolpakçıl, A.E.; Karaca, B.B. Investigation of a natural pH-indicator dye for nanofibrous wound dressings. In Proceedings of the IOP Conference Series: Materials Science and Engineering, AUTEX, Istanbul, Turkey, 20–22 June 2018; IOP Publishing: Bristol, UK, 2018; Volume 460, p. 012020. [Google Scholar]
- Guinovart, T.; Valdés-Ramírez, G.; Windmiller, J.R.; Andrade, F.J.; Wang, J. Bandage-Based Wearable Potentiometric Sensor for Monitoring Wound pH. Electroanalysis 2014, 26, 1345–1353. [Google Scholar] [CrossRef]
- Kassal, P.; Zubak, M.; Scheipl, G.; Mohr, G.J.; Steinberg, M.D.; Murković Steinberg, I. Smart bandage with wireless connectivity for optical monitoring of pH. Sens. Actuators B Chem. 2017, 246, 455–460. [Google Scholar] [CrossRef]
- Geltmeyer, J.; Vancoillie, G.; Steyaert, I.; Breyne, B.; Cousins, G.; Lava, K.; Hoogenboom, R.; De Buysser, K.; De Clerck, K. Dye modification of nanofibrous silicon oxide membranes for colorimetric HCl and NH3 sensing. Adv. Funct. Mater. 2016, 26, 5987–5996. [Google Scholar] [CrossRef]
- Jeevarathinam, A.S.; Varathan, E.; Ravindran, E.; Somanathan, N.; Subramanian, V.; Mandal, A.B.; Sudha, J.D.; Ramakrishnan, R. A solution processable fluorene–fluorenone oligomer with aggregation induced emission enhancement. Chem. Commun. 2013, 49, 10742–10744. [Google Scholar]
- Suleymanov, A.A.; Doll, M.; Ruggi, A.; Scopelliti, R.; Fadaei-Tirani, F.; Severin, K. Synthesis of tetraarylethene luminogens by C−H vinylation of aromatic compounds with triazenes. Angew. Chem. Int. Ed. 2020, 59, 9957–9961. [Google Scholar] [CrossRef] [PubMed]
- Atzori, L.; Iera, A.; Morabito, G.; Nitti, M. The Social Internet of Things (SIoT)—When social networks meet the Internet of Things: Concept, architecture and network characterization. Comput. Netw. 2012, 56, 3594–3608. [Google Scholar] [CrossRef]
- Bandodkar, A.J.; Jeerapan, I.; Wang, J. Wearable Chemical Sensors: Present Challenges and Future Prospects. ACS Sens. 2016, 1, 464–482. [Google Scholar] [CrossRef]
- Domingo, M.C. An overview of the Internet of Things for people with disabilities. J. Netw. Comput. Appl. 2012, 35, 584–596. [Google Scholar] [CrossRef]
- Trung, T.Q.; Lee, N.-E. Flexible and Stretchable Physical Sensor Integrated Platforms for Wearable Human-Activity Monitoringand Personal Healthcare. Adv. Mater. 2016, 28, 4338–4372. [Google Scholar] [CrossRef]
- Corzo, D.; Tostado-Blázquez, G.; Baran, D. Flexible electronics: Status, challenges and opportunities. Front. Electron. 2020, 1, 594003. [Google Scholar] [CrossRef]
- Shirakawa, H.; Louis, E.J.; MacDiarmid, A.G.; Chiang, C.K.; Heeger, A.J. Synthesis of electrically conducting organic polymers: Halogen derivatives of polyacetylene, (CH). J. Chem. Soc. Chem. Commun. 1977, 16, 578–580. [Google Scholar] [CrossRef]
- Chittick, R.C.; Alexander, J.H.; Sterling, H.F. The Preparation and Properties of Amorphous Silicon. J. Electrochem. Soc. 1969, 116, 77. [Google Scholar] [CrossRef]
- Wong, W.S.; Salleo, A. Flexible Electronics: Materials and Applications; Springer Science & Business Media: Berlin/Heidelberg, Germany, 2009; Volume 11, ISBN 0387743634. [Google Scholar]
- Oh, J.Y.; Rondeau-Gagné, S.; Chiu, Y.-C.; Chortos, A.; Lissel, F.; Wang, G.-J.N.; Schroeder, B.C.; Kurosawa, T.; Lopez, J.; Katsumata, T.; et al. Intrinsically stretchable and healable semiconducting polymer for organic transistors. Nature 2016, 539, 411–415. [Google Scholar] [CrossRef]
- Kang, J.; Son, D.; Wang, G.-J.N.; Liu, Y.; Lopez, J.; Kim, Y.; Oh, J.Y.; Katsumata, T.; Mun, J.; Lee, Y.; et al. Tough and Water-Insensitive Self-Healing Elastomer for Robust Electronic Skin. Adv. Mater. 2018, 30, 1706846. [Google Scholar] [CrossRef] [PubMed]
- Bettinger, C.J.; Bao, Z. Biomaterials-based organic electronic devices. Polym. Int. 2010, 59, 563–567. [Google Scholar] [CrossRef]
- Irimia-Vladu, M.; Troshin, P.A.; Reisinger, M.; Shmygleva, L.; Kanbur, Y.; Schwabegger, G.; Bodea, M.; Schwödiauer, R.; Mumyatov, A.; Fergus, J.W.; et al. Biocompatible and Biodegradable Materials for Organic Field-Effect Transistors. Adv. Funct. Mater. 2010, 20, 4069–4076. [Google Scholar] [CrossRef]
- Liu, H.; Jian, R.; Chen, H.; Tian, X.; Sun, C.; Zhu, J.; Yang, Z.; Sun, J.; Wang, C. Application of Biodegradable and Biocompatible Nanocomposites in Electronics: Current Status and Future Directions. Nanomaterials 2019, 9, 950. [Google Scholar] [CrossRef] [PubMed]
- Trung, T.Q.; Ramasundaram, S.; Hwang, B.-U.; Lee, N.-E. An All-Elastomeric Transparent and Stretchable Temperature Sensor for Body-Attachable Wearable Electronics. Adv. Mater. 2016, 28, 502–509. [Google Scholar] [CrossRef]
- Kassal, P.; Steinberg, I.M. System Architectures in Wearable Electrochemical Sensors. Electroanalysis 2016, 28, 1149–1169. [Google Scholar]
- Milne, S.D.; Seoudi, I.; Al Hamad, H.; Talal, T.K.; Anoop, A.A.; Allahverdi, N.; Zakaria, Z.; Menzies, R.; Connolly, P. A wearable wound moisture sensor as an indicator for wound dressing change: An observational study of wound moisture and status. Int. Wound J. 2016, 13, 1309–1314. [Google Scholar] [CrossRef] [PubMed]
- Bandodkar, A.J.; Molinnus, D.; Mirza, O.; Guinovart, T.; Windmiller, J.R.; Valdés-Ramírez, G.; Andrade, F.J.; Schöning, M.J.; Wang, J. Epidermal tattoo potentiometric sodium sensors with wireless signal transduction for continuous non-invasive sweat monitoring. Biosens. Bioelectron. 2014, 54, 603–609. [Google Scholar] [CrossRef] [PubMed]
- Lee, H.; Choi, T.K.; Lee, Y.B.; Cho, H.R.; Ghaffari, R.; Wang, L.; Choi, H.J.; Chung, T.D.; Lu, N.; Hyeon, T.; et al. A graphene-based electrochemical device with thermoresponsive microneedles for diabetes monitoring and therapy. Nat. Nanotechnol. 2016, 11, 566–572. [Google Scholar] [CrossRef]
- Lisak, G.; Arnebrant, T.; Ruzgas, T.; Bobacka, J. Textile-based sampling for potentiometric determination of ions. Anal. Chim. Acta 2015, 877, 71–79. [Google Scholar] [CrossRef]
- Kim, Y.H.; Kim, S.J.; Kim, Y.-J.; Shim, Y.-S.; Kim, S.Y.; Hong, B.H.; Jang, H.W. Self-Activated Transparent All-Graphene Gas Sensor with Endurance to Humidity and Mechanical Bending. ACS Nano 2015, 9, 10453–10460. [Google Scholar] [CrossRef]
- Gao, W.; Emaminejad, S.; Nyein, H.Y.Y.; Challa, S.; Chen, K.; Peck, A.; Fahad, H.M.; Ota, H.; Shiraki, H.; Kiriya, D.; et al. Fully integrated wearable sensor arrays for multiplexed in situ perspiration analysis. Nature 2016, 529, 509–514. [Google Scholar] [CrossRef]
- Pankratov, D.; González-Arribas, E.; Blum, Z.; Shleev, S. Tear Based Bioelectronics. Electroanalysis 2016, 28, 1250–1266. [Google Scholar] [CrossRef]
- Kim, J.; Imani, S.; de Araujo, W.R.; Warchall, J.; Valdés-Ramírez, G.; Paixão, T.R.L.C.; Mercier, P.P.; Wang, J. Wearable salivary uric acid mouthguard biosensor with integrated wireless electronics. Biosens. Bioelectron. 2015, 74, 1061–1068. [Google Scholar] [CrossRef]
- Stoppa, M.; Chiolerio, A. Wearable Electronics and Smart Textiles: A Critical Review. Sensors 2014, 14, 11957–11992. [Google Scholar] [CrossRef]
- Mishra, R.K.; Hubble, L.J.; Martín, A.; Kumar, R.; Barfidokht, A.; Kim, J.; Musameh, M.M.; Kyratzis, I.L.; Wang, J. Wearable Flexible and Stretchable Glove Biosensor for On-Site Detection of Organophosphorus Chemical Threats. ACS Sens. 2017, 2, 553–561. [Google Scholar] [CrossRef]
- Grancarić, A.M.; Jerković, I.; Koncar, V.; Cochrane, C.; Kelly, F.M.; Soulat, D.; Legrand, X. Conductive polymers for smart textile applications. J. Ind. Text. 2017, 48, 612–642. [Google Scholar] [CrossRef]
- Li, L.; Fan, T.; Hu, R.; Liu, Y.; Lu, M. Surface micro-dissolution process for embedding carbon nanotubes on cotton fabric as a conductive textile. Cellulose 2017, 24, 1121–1128. [Google Scholar] [CrossRef]
- Trovato, V.; Teblum, E.; Kostikov, Y.; Pedrana, A.; Re, V.; Nessim, G.D.; Rosace, G. Sol-gel approach to incorporate millimeter-long carbon nanotubes into fabrics for the development of electrical-conductive textiles. Mater. Chem. Phys. 2020, 240, 122218. [Google Scholar] [CrossRef]
- Katragadda, R.B.; Xu, Y. A novel intelligent textile technology based on silicon flexible skins. Sens. Actuators A 2008, 143, 169–174. [Google Scholar] [CrossRef]
- Khan, Y.; Thielens, A.; Muin, S.; Ting, J.; Baumbauer, C.; Arias, A.C. A New Frontier of Printed Electronics: Flexible Hybrid Electronics. Adv. Mater. 2020, 32, 1905279. [Google Scholar] [CrossRef] [PubMed]
- Park, J.; Martinez, M.M.; Berlinger, M.H.; Ringrose, A.; Clifton, D.J.; McKinney, S.E.; Amit, G. Wristband health tracker. U.S. Patent 749002, 9 February 2016. [Google Scholar]
- Wu, W.; Haick, H. Materials and Wearable Devices for Autonomous Monitoring of Physiological Markers. Adv. Mater. 2018, 30, 1705024. [Google Scholar] [CrossRef] [PubMed]
- Tamura, T.; Maeda, Y.; Sekine, M.; Yoshida, M. Wearable photoplethysmographic sensors—Past and present. Electronics 2014, 3, 282–302. [Google Scholar] [CrossRef]
- Poh, M.Z.; Swenson, N.C.; Picard, R.W. Motion-tolerant magnetic earring sensor and wireless earpiece for wearable photoplethysmography. IEEE Trans. Inf. Technol. Biomed. 2010, 14, 786–794. [Google Scholar] [CrossRef]
- Zhang, T.T.; Ser, W.; Daniel, G.Y.T.; Zhang, J.; Yu, J.; Chua, C.; Louis, I.M. Sound based heart rate monitoring for wearable systems. In Proceedings of the 2010 International Conference on Body Sensor Networks, Singapore, 7–9 June 2010; pp. 139–143. [Google Scholar]
- Lee, H.E.; Shin, J.H.; Park, J.H.; Hong, S.K.; Park, S.H.; Lee, S.H.; Lee, J.H.; Kang, I.S.; Lee, K.J. Micro Light-Emitting Diodes for Display and Flexible Biomedical Applications. Adv. Funct. Mater. 2019, 29, 1808075. [Google Scholar] [CrossRef]
- Karlen, W.; Raman, S.; Ansermino, J.M.; Dumont, G.A. Multiparameter respiratory rate estimation from the photoplethysmogram. IEEE Trans. Bio-Med. Eng. 2013, 60, 1946–1953. [Google Scholar] [CrossRef] [PubMed]
- Lee, J.; Kim, M.; Park, H.K.; Kim, I.Y. Motion Artifact Reduction in Wearable Photoplethysmography Based on Multi-Channel Sensors with Multiple Wavelengths. Sensors 2020, 20, 1493. [Google Scholar] [CrossRef] [PubMed]
- Pellicer, A.; Bravo, M.C. Near-infrared spectroscopy: A methodology-focused review. Semin. Fetal. Neonatal. Med. 2011, 16, 42–49. [Google Scholar] [CrossRef] [PubMed]
- Tremper, K.K. Pulse Oximetry. Chest 1989, 95, 713–715. [Google Scholar] [CrossRef]
- Wolf, M.; Wolf, U.; Toronov, V.; Michalos, A.; Paunescu, L.A.; Choi, J.H.; Gratton, E. Different Time Evolution of Oxyhemoglobin and Deoxyhemoglobin Concentration Changes in the Visual and Motor Cortices during Functional Stimulation: A Near-Infrared Spectroscopy Study. Neuroimage 2002, 16, 704–712. [Google Scholar] [CrossRef]
- Fallgatter, A.J.; Strik, W.K. Right frontal activation during the continuous performance test assessed with near-infrared spectroscopy in healthy subjects. Neurosci. Lett. 1997, 223, 89–92. [Google Scholar] [CrossRef]
- Buzhan, P.; Dolgoshein, B.; Ilyin, A.; Kantserov, V.; Kaplin, V.; Karakash, A.; Pleshko, A.; Popova, E.; Smirnov, S.; Volkov, Y.U.; et al. The advanced study of silicon photomultiplier. In Advanced Technology and Particle Physics; Astroparticle, Particle, Space Physics, Radiation Interaction, Detectors and Medical Physics Applications; World Scientific: Singapore, 2002; Volume 1, pp. 717–728. ISBN 978-981-238-180-4. [Google Scholar]
- Finocchiaro, P.; Pappalardo, A.; Cosentino, L.; Belluso, M.; Billotta, S.; Bonanno, G.; Carbone, B.; Condorelli, G.; Di Mauro, S.; Fallica, G.; et al. Characterization of a novel 100-channel silicon photomultiplier—Part II: Charge and time. IEEE Trans. Electron. Dev. 2008, 55, 2765–2773. [Google Scholar] [CrossRef]
- Pagano, R.; Corso, D.; Lombardo, S.; Valvo, G.; Sanfilippo, D.N.; Fallica, G.; Libertino, S. Dark current in silicon photomultiplier pixels: Data and model. IEEE Trans. Electron. Dev. 2012, 59, 2410–2416. [Google Scholar] [CrossRef]
- Santangelo, M.F.; Sciuto, E.L.; Busacca, A.C.; Petralia, S.; Conoci, S.; Libertino, S. Si-photomultipliers for bio-sensing applications. IEEE J. Sel. Top. Quantum Electron. 2016, 22, 6900307. [Google Scholar] [CrossRef]
- Santangelo, M.F.; Libertino, S.; Turner, A.; Filippini, D.; Mak, W. Integrating printed microfluidics with silicon photomultipliers for miniaturised and highly sensitive ATP bioluminescence detection. Biosens. Bioelectron. 2018, 99, 464–470. [Google Scholar] [CrossRef]
- Sciuto, E.L.; Coniglio, M.A.; Corso, D.; Van der Meer, J.R.; Acerbi, F.; Gola, A.; Libertino, S. Biosensor in monitoring water quality and safety: An example of miniaturizable whole-cell based sensor for Hg2+ optical detection in water. Water 2019, 11, 1986. [Google Scholar] [CrossRef]
- Petralia, S.; Cosentino, T.; Sinatra, F.; Favetta, M.; Fiorenza, P.; Bongiorno, C.; Sciuto, L.C.; Conoci, S.; Libertino, S. Silicon Nitride Surfaces as Active Substrate for Electrical DNA Biosensors. Sens. Actuators B 2017, 252, 492–502. [Google Scholar] [CrossRef]
- Maira, G.; Mazzillo, M.; Libertino, S.; Fallica, G.; Lombardo, S. Crucial aspects for the use of silicon photomultiplier devices in Continuous Wave functional Near Infrared Spectroscopy. Biomed. Opt. Express 2018, 9, 4679–4688. [Google Scholar] [CrossRef]
- De Luca, G.; Bonaccorsi, P.; Trovato, V.; Mancuso, A.; Papalia, T.; Pistone, A.; Casaletto, M.P.; Mezzi, A.; Brunetti, B.; Minuti, L.; et al. Tripodal tris-disulfides as capping agents for a controlled mixed functionalization of gold nanoparticles. New J. Chem. 2018, 42, 16436–16440. [Google Scholar] [CrossRef]
- Pagano, R.; Libertino, S.; Sanfilippo, D.; Fallica, G.; Lombardo, S. Improvement of Sensitivity in Continuous Wave Near Infra-Red Spectroscopy Systems by using Silicon Photo-Multipliers. Biomed. Opt. Express 2016, 7, 1183–1192. [Google Scholar] [CrossRef][Green Version]
- Kaneta, T.; Alahmad, W.; Varanusupakul, P. Microfluidic paper-based analytical devices with instrument-free detection and miniaturized portable detectors. Appl. Spectrosc. Rev. 2019, 54, 117–141. [Google Scholar] [CrossRef]
- Yan, L.; Bae, J.; Lee, S.; Roh, T.; Song, K.; Yoo, H.J. A 3.9 mW 25-electrode reconfigured sensor for wearable cardiac monitoring system. IEEE J. Solid-State Circuits 2011, 4, 353–364. [Google Scholar] [CrossRef]
- Ravanshad, N.; Rezaee-Dehsorkh, H.; Lotfi, Y.; Lian, R. A level crossing based QRS-detection algorithm for wearable ECG sensors. IEEE J. Biomed. Health Inform. 2014, 18, 183–192. [Google Scholar] [CrossRef]
- Mukhopadhyay, S.C. Wearable Sensors for Human Activity Monitoring: A Review. IEEE Sens. J. 2015, 15, 1321. [Google Scholar] [CrossRef]
- Khan, Y.; Garg, M.; Gui, Q.; Schadt, M.; Gaikwad, A.; Han, D.; Yamamoto, N.A.D.; Hart, P.; Welte, R.; Wilson, W.; et al. Flexible hybrid electronics: Direct interfacing of soft and hard electronics for wearable health monitoring. Adv. Funct. Mater. 2016, 26, 8764. [Google Scholar] [CrossRef]
- Jeong, H.; Wang, X.; Ha, T.; Mitbander, V.; Yang, X.; Dai, Z.; Qiao, S.; Shen, L.; Sun, N.; Lu, V. Modular and Reconfigurable Wireless E-Tattoos for Personalized Sensing. Adv. Mater. Technol. 2019, 4, 1900117. [Google Scholar] [CrossRef]
- Chung, H.U.; Kim, B.H.; Lee, J.Y.; Lee, J.; Xie, Z.; Ibler, E.M.; Lee, K.; Banks, A.; Jeong, J.Y.; Kim, J.; et al. Binodal, wireless epidermal electronic systems with in-sensor analytics for neonatal intensive care. Science 2019, 363, 0780. [Google Scholar] [CrossRef]
- Brand, O. Microsensor integration into systems-on-chip. Proc. IEEE 2006, 94, 1160–1176. [Google Scholar] [CrossRef]
- Dudde, R.; Thomas, V.; Piechotta, G.; Hintsche, R. Computer-aided continuous drug infusion: Setup and test of a mobile closed-loop system for the continuous automated infusion of insulin. Information Technology in Biomedicine. IEEE Trans. 2006, 10, 395–402. [Google Scholar]
- Coyle, S.; King-Tong, L.; Moyna, N.; O’Gorman, D.; Diamond, D.; Di Francesco, F.; Costanzo, D.; Salvo, P.; Trivella, M.G.; De Rossi, D.E.; et al. BIOTEX-Biosensing textiles for personalised healthcare management. IEEE Trans. Inf. Technol. Biomed. 2010, 14, 364–370. [Google Scholar] [CrossRef]
- Curone, D.; Secco, E.L.; Tognetti, A.; Loriga, G.; Dudnik, G.; Risatti, M.; Whyte, R.; Bonfiglio, A.; Magenes, G. Smart garments for emergency operators: The ProeTEX project. IEEE Trans. Inf. Technol. Biomed. 2010, 14, 694–701. [Google Scholar] [CrossRef]
- Wang, L.; Yang, G.Z.; Huang, J.; Zhang, J.; Yu, L.; Nie, Z. Cumming DRS: A wireless biomedical signal interface system-on-chip for body sensor networks. IEEE Trans. Inf. Technol. Biomed. 2010, 4, 112–117. [Google Scholar]
- Ahn, C.H.; Jin-Woo, C.; Beaucage, G.; Nevin, J.H.; Jeong-Bong, L.; Puntambekar, A.; Lee, J.Y. Disposable smart lab on a chip for point-of-care clinical diagnostics. Proc. IEEE 2004, 92, 154–173. [Google Scholar] [CrossRef]
- Kamila, S. Introduction, Classification and Applications of Smart Materials: An Overview. Am. J. Appl. Sci. 2013, 10, 876. [Google Scholar] [CrossRef]
- Ferrara, M.; Bengisu, M. Intelligent Design with Chromogenic Materials. J. Int. Color Assoc. 2014, 13, 54–66. [Google Scholar]
- Li, Q. Intelligent Stimuli-Responsive Materials: From Well-Defined Nanostructures to Applications; John Wiley & Sons: Hoboken, NJ, USA, 2013. [Google Scholar]
- Ferrara, M.; Bengisu, M. Materials That Change Color; Springer: Cham, Switzerland, 2014; pp. 9–60. [Google Scholar]
- Loutfi, A.; Coradeschi, S.; Mani, G.K.; Shankar, P.; Rayappan, J.B.B. Electronic Noses for Food Quality: A Review. J. Food Eng. 2015, 144, 103–111. [Google Scholar] [CrossRef]
- Elyasian, I. Smart Materials and New Technologies. In International Conference on Modern Research in Civil Engineering, Architectural, and Urban Development; SID Publications, IRIB International Center: Tehran, Iran, 2015. [Google Scholar]
- Sadeghi, K.; Jeong-Yeol, Y.; Jongchul, S. Chromogenic Polymers and Their Packaging Applications: A Review. Polym. Rev. 2020, 60, 442–492. [Google Scholar] [CrossRef]
- Wang, L.; Li, Q. Photochromism into Nanosystems: Towards Lighting up the Future Nanoworld. Chem. Soc. Rev. 2018, 47, 1044–1097. [Google Scholar] [CrossRef]
- Zola, R.S.; Bisoyi, H.K.; Wang, H.; Urbas, A.M.; Bunning, T.J.; Li, Q. Dynamic Control of Light Direction Enabled by Stimuli-Responsive Liquid Crystal Gratings. Adv. Mater. 2019, 31, 1806172. [Google Scholar] [CrossRef]
- Mortimer, R.J.; Dyer, A.L.; Reynolds, J. Electrochromic Organic and Polymeric Materials for Display Applications. Display 2006, 27, 2–18. [Google Scholar] [CrossRef]
- Fleischmann, C.; Lievenbruck, M.; Ritter, H. Polymersand. Dyes: Developmentsand Applications. Polymers 2015, 7, 717–746. [Google Scholar] [CrossRef]
- Wang, H.; Bisoyi, K.; Wang, L.; Urbas, A.M.; Bunning, T.J.; Li, Q. Photochemically and Thermally Driven Full-Color Reflection in a Self-Organized Helical Superstructure Enabled by a Halogen-Bonded Chiral Molecular Switch. Angew. Chem. Int. Ed. 2018, 57, 1627–1631. [Google Scholar] [CrossRef] [PubMed]
- Finlayson, C.E.; Baumberg, J. Polymer Opals as Novel Photonic Materials. Polym. Int. 2013, 62, 1403–1407. [Google Scholar] [CrossRef]
- Ritter, A. Colour- and optically changing smart materials. In Smart Materials in Architecture, Interior Architecture and Design; Birkhäuser: Basel, Switzerland, 2007; pp. 72–97. [Google Scholar]
- Liu, Y.; Mills, E.N.; Composto, R.J. Tuning Optical Properties of Gold Nanorods in Polymer Films through Thermal Reshaping. J. Mater. Chem. 2009, 19, 2704–2709. [Google Scholar] [CrossRef]
- Seeboth, A.; Lötzsch, D. Thermochromic Polymers. In Encyclopedia of Polymer Science and Technology; John Wiley & Sons, Inc.: Hoboken, NJ, USA, 2003. [Google Scholar]
- Kreyenschmidt, J.; Christiansen, H.; Hübner, A.; Raab, V.; Petersen, B. A novel photochromic time–temperature indicator to support cold chain management. Int. J. Food Sci. Technol. 2010, 45, 208–215. [Google Scholar] [CrossRef]
- Brizio, A.P.D.R.; Prentice, C. Use of Smart Photochromic Indicator for Dynamic Monitoring of the Shelf Life of Chilled Chicken Based Products. Meat Sci. 2014, 96, 1219–1226. [Google Scholar] [CrossRef]
- Chowdhury, M.; Joshi, M.; Butola, B. Photochromic and Thermochromic Colorants in Textile Applications. J. Eng. Fiber Fabr. 2014, 9, 107–123. [Google Scholar] [CrossRef]
- Seeboth, A.; Lötzsch, D.; Ruhmann, R.; Muehling, O. Thermochromic Polymers Function by Design. Chem. Rev. 2014, 114, 3037–3068. [Google Scholar] [CrossRef]
- Crano, J.C.; Guglielmetti, R.J. Organic Photochromic and Thermochromic Compounds: Volume 2: Physicochemical Studies, Biological Applications, and Thermochromism; Springer: New York, NY, USA, 2002. [Google Scholar]
- Seeboth, A.; Klukowska, A.; Ruhmann, R.; Lotzsch, D. Thermochromic Polymer Materials. Chin. J. Polym. Sci. 2007, 25, 123–135. [Google Scholar] [CrossRef]
- Costa, C.M.; Costa, P.; Lanceros-Mendez, S. Overview on Lightweight, Multifunctional Materials. In Advanced Lightweight Multifunctional Materials; Elsevier: Amsterdam, The Netherlands, 2021; pp. 1–24. [Google Scholar]
- Mortimer, R.J. Electrochromic Materials. Chem. Soc. Rev. 1997, 26, 147–156. [Google Scholar] [CrossRef]
- Arman, S. Electrochromic Materials for Display Applications: An Introduction. J. New Mater. Electrochem. Syst. 2001, 4, 173–180. [Google Scholar]
- Bamfield, P. Chromic Phenomena: Technological Applications of Colour Chemistry; Royal Society of Chemistry: London, UK, 2010. [Google Scholar]
- Sniechowski, M. Structure and Dynamics of Conducting Poly(Aniline) Based Compounds. Ph.D. Dissertation, AGH University of Science and Technology, Krakow, Poland, 2006. [Google Scholar]
- Somani, P.R.; Radhakrishnan, S. Electrochromic Materials and Devices: Present and Future. Mater. Chem. Phys. 2003, 77, 117–133. [Google Scholar] [CrossRef]
- Ramkumar, V.; Ju, S. Fine-tuning of blue-emitting pyrazoline using phenyl and thiophene terminal group substituents. Opt. Mater. Express 2017, 7, 185–194. [Google Scholar] [CrossRef]
- Zhang, X.; Wu, S.; Gao, Z.; Lee, C.; Lee, S.; Kwong, H.-L. Pyrazoline Derivatives for Blue Color Emitter in Organic Electroluminescent Devices. Thin Solid Films 2000, 371, 40–46. [Google Scholar] [CrossRef]
- Li, G.; Liu, W.-S.; Yang, S.-L.; Zhang, L.; Bu, R.; Gao, E.-Q. Anion-Afforded Functions of Ionic Metal–Organic Frameworks: Ionochromism, Anion Conduction, and Catalysis. Inorg. Chem. 2022, 61, 902–910. [Google Scholar] [CrossRef]
- Razavi, B.; Roghani-Mamaqani, H.; Salami-Kalajahi, M. Development of highly sensitive metal-ion chemosensor and key-lock anticounterfeiting technology based on oxazolidine. Sci. Rep. 2022, 12, 1079. [Google Scholar] [CrossRef]
- De Campos Ventura-Camargo, B.; Marin-Morales, M.A. Azo Dyes: Characterization and Toxicity–A Review. Text. Light Ind. Sci. Technol. 2013, 2, 85–103. [Google Scholar]
- Roberts, D.R.; Holder, S.J. Mechanochromic Systems for the Detection of Stress, Strain and Deformation in Polymeric Materials. J. Mater. Chem. 2011, 21, 8256–8268. [Google Scholar] [CrossRef]
- Seeboth, A.; Loetzsch, D.; Ruhmann, R. Piezochromic Polymer Materials Displaying Pressure Changes in Bar-Ranges. Materials 2012, 1, 139–142. [Google Scholar] [CrossRef]
- Luo, M.; Zhou, X. Organic Small-Molecule Mechanofluorochromic Materials. RSC Smart Mater. 2014, 8, 7–71. [Google Scholar]
- Sui, Q.; Ren, X.-T.; Dai, Y.-X.; Wang, K.; Li, W.-T.; Gong, T.; Fang, J.-J.; Zou, B.; Gao, E.-Q.; Wang, L. Piezochromism and hydrochromism through electron transfer: New stories for viologen materials. Chem. Sci. 2017, 8, 2758–2768. [Google Scholar] [CrossRef] [PubMed]
- Zhang, X.; Wei, Y.; Chi, Z.; Xu, J. Organic-Inorganic Complex Mechanofluorochromic Materials. ChemInform 2014, 46, 72–113. [Google Scholar]
- Wang, L.; Liu, L.; Xu, B.; Tian, W. Recent Advances in Mechanism of AIE Mechanochromic Materials. Chem. Res. Chin. Univ. 2021, 37, 100–109. [Google Scholar] [CrossRef]
- Kang, D.; Pikhitsa, P.V.; Choi, Y.W.; Lee, C.; Shin, S.S.; Piao, L.; Park, B.; Suh, K.-Y.; Kim, T.; Choi, M. Ultrasensitive mechanical crack-based sensor inspired by the spider sensory system. Nature 2014, 516, 222–226. [Google Scholar] [CrossRef]
- Li, L.L.; Sun, H.; Fang, C.J.; Yuan, Q.; Sun, L.D.; Yan, C.H. Mesostructured Hybrids Containing Potential Donors and Acceptors with Molecular-Scale and Meso-Scale Segregation and Ordering: Toward the Development of Smart Materials through Hierarchical Self-Assembly. Chem. Mater. 2009, 21, 4589–4597. [Google Scholar] [CrossRef]
- Jiang, Y. An outlook review: Mechanochromic materials and their potential for biological and healthcare applications. Mater. Sci. Eng. C 2014, 45, 682–689. [Google Scholar] [CrossRef]
- Seki, T.; Tokodai, N.; Omagari, S.; Nakanishi, T.; Hasegawa, Y.; Iwasa, T.; Taketsugu, T.; Ito, H. Luminescent Mechanochromic 9-Anthryl Gold (I) isocyanide Complex with an Emission Maximum at 900 nm after Mechanical Stimulation. J. Am. Chem. Soc. 2017, 139, 6514–6517. [Google Scholar] [CrossRef]
- Rankin, J.M.; Zhang, Q.; LaGasse, M.K.; Zhang, Y.; Askim, J.R.; Suslick, K.S. Solvatochromic Sensor Array for the Identification of Common Organic Solvents. Analyst 2015, 140, 2613–2617. [Google Scholar] [CrossRef]
- Marini, A.; Munoz-Losa, A.; Biancardi, A.; Mennucci, B. What is Solvatochromism? J. Phys. Chem. B 2010, 114, 17128–17135. [Google Scholar] [CrossRef]
- Agbaria, R.A.; Oldham, P.B.; McCarroll, M.; McGown, L.B.; Warner, I.M. Molecular Fluorescence, Phosphorescence, and Chemiluminescence Spectrometry. Anal. Chem. 2002, 74, 3952–3962. [Google Scholar] [CrossRef]
- Nigam, S.; Rutan, S. Principles and Applications of Solvatochromism. Appl. Spectrosc. 2001, 55, 362–370. [Google Scholar] [CrossRef]
- Sengupta, A.; Behera, J. Smart Chromic Colorants Draw Wide Attention for the Growth of Future Intelligent Textile Materials. J. Adv. Res. Manuf. Mater. Sci. Metallurg. Eng. 2014, 1, 89–112. [Google Scholar]
- Ding, L.; Zhang, Z.; Li, X.; Su, J. Highly sensitive determination of low-level water content in organic solvents using novel solvatochromic dyes based on thioxanthone. Chem. Commun. 2013, 49, 7319–7321. [Google Scholar] [CrossRef] [PubMed]
- Kleemann, M.; Suisalu, A.; Kikas, J. Polymer Film Doped with a Solvatochromic Dye for Humidity Measurement, Optical Materials and Applications. Opt. Mater. Appl. 2006, 5956, 59460N. [Google Scholar]
- Sun, C.; Zhang, Y.; Fan, Y.; Li, Y.; Li, J. Mannose–Escherichia coli Interaction in the Presence of Metal Cations Studied in Vitro by Colorimetric Polydiacetylene/Glycolipid Liposomes. J. Inorg. Biochem. 2004, 98, 925–930. [Google Scholar] [CrossRef]
- Zhang, W.; Li, H.; Hopmann, E.; Elezzabi, A.Y. Nanostructured inorganic electrochromic materials for light applications. Nanophotonics 2021, 10, 825–850. [Google Scholar] [CrossRef]
- Liu, J.; He, P.; Yan, J.; Fang, X.; Peng, J.; Liu, K.; Fang, Y. An Organometallic Super-Gelator with Multiple-Stimulus Responsive Properties. Adv. Mater. 2008, 20, 2508–2511. [Google Scholar] [CrossRef]
- Charych, D.H.; Nagy, J.O.; Spevak, W.; Bednarski, M.D. Direct Colorimetric Detection of a Receptor-Ligand Interaction by a Polymerized Bilayer Assembly. Science 1993, 261, 585–588. [Google Scholar] [CrossRef]
- Kim, C.; Hong, C.; Lee, K. Structures and strategies for enhanced sensitivity of polydiacetylene(PDA) based biosensor platforms. Biosens. Bioelectron. 2021, 181, 113120. [Google Scholar] [CrossRef]
- Berkeley Lab. Colorimetric and Fluorescent Sensors for Rapid and Direct Detection of Influenza, E. coli and Other Analytes, 2009. Available online: http://www.lbl.gov/tt/techs/lbnl0965.html (accessed on 27 July 2022).
- Chutvirasakul, B.; Nuchtavorn, N.; Macka, M.; Suntornsuk, L. Distance-based paper device using polydiacetylene liposome as a chromogenic substance for rapid and in-field analysis of quaternary ammonium compounds. Anal. Bioanal. Chem. 2020, 412, 3221–3230. [Google Scholar] [CrossRef] [PubMed]
- Xu, J.; Tao, X.; Liu, X.; Yang, L. Wearable Eye Patch Biosensor for Noninvasive and Simultaneous Detection of Multiple Biomarkers in Human Tears. Anal. Chem. 2022, 94, 8659–8667. [Google Scholar] [CrossRef] [PubMed]
- de Castro, L.F.; de Freitas, S.V.; Duarte, L.C.; de Souza, J.A.C.; Paixão, T.R.L.C.; Coltro, W.K.T. Salivary diagnostics on paper microfluidic devices and their use as wearable sensors for glucose monitoring. Anal. Bioanal. Chem. 2019, 411, 4919–4928. [Google Scholar] [CrossRef] [PubMed]
- Koh, A.; Kang, D.; Xue, Y.; Lee, S.; Pielak, R.M.; Kim, J.; Hwang, T.; Min, S.; Banks, A.; Bastien, P.; et al. A soft, wearable microfluidic device for the capture, storage, and colorimetric sensing of sweat. Sci. Transl. Med. 2016, 8, 366ra165. [Google Scholar] [CrossRef] [PubMed]
- Ardalan, S.; Hosseinifard, M.; Vosough, M.; Golmohammadi, H. Towards smart personalized perspiration analysis: An IoT-integrated cellulose-based microfluidic wearable patch for smartphone fluorimetric multi-sensing of sweat biomarkers. Biosens. Bioelectron. 2020, 168, 112450. [Google Scholar] [CrossRef]
- Zheng, Y.; Panatdasirisuk, W.; Liu, J.; Tong, A.; Xiang, Y.; Yang, S. Patterned, Wearable UV Indicators from Electrospun Photochromic Fibers and Yarns. Adv. Mater. Technol. 2020, 5, 2000564. [Google Scholar] [CrossRef]
- Liu, Y.; Li, H.; Feng, Q.; Su, H.; Li, D.; Shang, Y.; Chen, H.; Li, B.; Dong, H. A Three-Dimensional-Printed Recyclable, Flexible, and Wearable Device for Visualized UV, Temperature, and Sweat pH Sensing. ACS Omega 2022, 7, 9834–9845. [Google Scholar] [CrossRef]
- Ran, J.; Xu, R.; Xia, R.; Cheng, D.; Yao, J.; Bi, S.; Cai, G.; Wang, X. Carbon nanotube/polyurethane core–sheath nanocomposite fibers for wearable strain sensors and electro-thermochromic textiles. Smart Mater. Struct. 2021, 30, 075022. [Google Scholar] [CrossRef]
- He, Y.; Li, W.; Han, N.; Wang, J.; Zhang, X. Facile flexible reversible thermochromic membranes based on micro/nanoencapsulated phase change materials for wearable temperature sensor. Appl. Energy 2019, 247, 615–629. [Google Scholar] [CrossRef]
- Kim, D.-H.; Bae, J.; Lee, J.; Ahn, J.; Hwang, W.-T.; Ko, J.; Kim, I.-D. Porous Nanofiber Membrane: Rational Platform for Highly Sensitive Thermochromic Sensor. Adv. Funct. Mater. 2022, 32, 2200463. [Google Scholar] [CrossRef]
- Kim, D.S.; Lee, Y.H.; Kim, J.W.; Lee, H.; Jung, G.; Ha, J.S. A stretchable array of high-performance electrochromic devices for displaying skin-attached multi-sensor signals. Chem. Eng. J. 2022, 429, 132289. [Google Scholar] [CrossRef]
- Kim, M.; Jung, I.D.; Kim, Y.; Yun, J.; Gao, C.; Lee, H.-W.; Lee, S.W. An electrochromic alarm system for smart contact lenses. Sens. Actuators B Chem. 2020, 322, 128601. [Google Scholar] [CrossRef]
- Chaudhary, A.; Ghosh, T.; Pathak, D.K.; Kandpal, S.; Tanwar, M.; Rani, C.; Kumar, R. Prussian blue-based inorganic flexible electrochromism glucose sensor. IET Nanodielectrics 2021, 4, 165–170. [Google Scholar] [CrossRef]
- Trovato, V.; Mezzi, A.; Brucale, M.; Rosace, G.; Rosaria Plutino, M. Alizarin-functionalized organic-inorganic silane coatings for the development of wearable textile sensors. J. Colloid Interface Sci. 2022, 617, 463–477. [Google Scholar] [CrossRef] [PubMed]
- Lee, J.; Jun, H.; Kubota, Y.; Kim, T. Synthesis of red fluorescent dye with acid gas sensitive optical properties and fabrication of a washable and wearable textile sensor. Text. Res. J. 2021, 91, 2036–2052. [Google Scholar] [CrossRef]
- Hu, J.; Liu, Y.; Zhang, X.; Han, H.; Li, Z.; Han, T. Fabricating a mechanochromic AIE luminogen into a wearable sensor for volatile organic compound (VOC) detection. Dye. Pigment. 2021, 192, 109393. [Google Scholar] [CrossRef]
- Xu, H.; Zhang, M.K.; Lu, Y.F.; Li, J.J.; Ge, S.J.; Gu, Z.Z. Dual-Mode Wearable Strain Sensor Based on Graphene/Colloidal Crystal Films for Simultaneously Detection of Subtle and Large Human Motions. Adv. Mater. Technol. 2020, 5, 1901056. [Google Scholar] [CrossRef]
- Khan, M.R.R.; Oh, S.; Choi, G.; Lee, H.S. Highly sensitive, fast and wide dynamic range lactate sensor containing solvatochromic sensing membrane by combining the capacitance-to-phase conversion technique. Sens. Actuators B Chem. 2020, 309, 127783. [Google Scholar] [CrossRef]
- Zhang, Q.; Wang, X.; Decker, V.; Meyerhoff, M.E. Plasticizer-Free Thin-Film Sodium-Selective Optodes Inkjet-Printed on Transparent Plastic for Sweat Analysis. ACS Appl. Mater. Interfaces 2020, 12, 25616–25624. [Google Scholar] [CrossRef]
- El-Naggar, M.E.; Abu Ali, O.A.; Saleh, D.I.; Abu-Saied, M.A.; Khattab, T.A. Preparation of green and sustainable colorimetric cotton assay using natural anthocyanins for sweat sensing. Int. J. Biol. Macromol. 2021, 190, 894–903. [Google Scholar] [CrossRef]
- Reda, A.; El-Safty, S.A.; Selim, M.M.; Shenashen, M.A. Optical glucose biosensor built-in disposable strips and wearable electronic devices. Biosens. Bioelectron. 2021, 185, 113237. [Google Scholar] [CrossRef]
- Lei, Y.; Zhao, W.; Zhang, Y.; Jiang, Q.; He, J.-H.; Baeumner, A.J.; Wolfbeis, O.S.; Wang, Z.L.; Salama, K.N.; Alshareef, H.N. A MXene-Based Wearable Biosensor System for High-Performance In Vitro Perspiration Analysis. Small 2019, 15, 1901190. [Google Scholar] [CrossRef] [PubMed]
- Maciel, V.B.V.; Yoshida, C.M.P.; Franco, T.T. Development of a prototype of a colourimetric temperature indicator for monitoring food quality. J. Food Eng. 2012, 111, 21–27. [Google Scholar] [CrossRef]
- Beauchamp, M.; Lands, L.C. Sweat-testing: A review of current technical requirements. Pediatr. Pulmonol. 2005, 39, 507–511. [Google Scholar] [CrossRef] [PubMed]
- Jadoon, S.; Karim, S.; Akram, M.R.; Kalsoom Khan, A.; Zia, M.A.; Siddiqi, A.R.; Murtaza, G. Recent Developments in Sweat Analysis and Its Applications. Int. J. Anal. Chem. 2015, 2015, 164974. [Google Scholar] [CrossRef] [PubMed]
- Serag, A.; Shakkour, Z.; Halboup, A.M.; Kobeissy, F.; Farag, M.A. Sweat metabolome and proteome: Recent trends in analytical advances and potential biological functions. J. Proteom. 2021, 246, 104310. [Google Scholar] [CrossRef]
- Granger, C.B.; Goldberg, R.J.; Dabbous, O.; Pieper, K.S.; Eagle, K.A.; Cannon, C.P.; Van De Werf, F.; Avezum, A.; Goodman, S.G.; Flather, M.D.; et al. Predictors of hospital mortality in the global registry of acute coronary events. Arch. Intern. Med. 2003, 163, 2345–2353. [Google Scholar] [CrossRef] [PubMed]
- Patterson, M.J.; Galloway, S.D.R.; Nimmo, M.A. Effect of induced metabolic alkalosis on sweat composition in men. Acta Physiol. Scand. 2002, 174, 41–46. [Google Scholar] [CrossRef] [PubMed]
- Morgan, D.; Cherny, V.V.; Murphy, R.; Katz, B.Z.; DeCoursey, T.E. The pH dependence of NADPH oxidase in human eosinophils. J. Physiol. 2005, 569, 419–431. [Google Scholar] [CrossRef]
- Casa, D.J.; Armstrong, L.E.; Hillman, S.K.; Montain, S.J.; Reiff, R.V.; Rich, B.S.; Roberts, W.O.; Stone, J.A. National athletic trainers’ association position statement: Fluid replacement for athletes. J. Athl. Train. 2000, 35, 212–224. [Google Scholar]
- Van der Schueren, L.; De Clerck, K. The Use of pH-indicator Dyes for pH-sensitive Textile Materials. Text. Res. J. 2010, 80, 590–603. [Google Scholar] [CrossRef]
- Schmid-Wendtner, M.H.; Korting, H.C. The pH of the Skin Surface and Its Impact on the Barrier Function. Skin. Pharmacol. Physiol. 2006, 19, 296–302. [Google Scholar] [CrossRef] [PubMed]
- Morgan, R.M.; Patterson, M.J.; Nimmo, M.A. Acute effects of dehydration on sweat composition in men during prolonged exercise in the heat. Acta Physiol. Scand. 2004, 182, 37–43. [Google Scholar] [CrossRef] [PubMed]
- Robinson, K.L.; Lawrence, N.S. Redox-Sensitive Copolymer: A Single-Component pH Sensor. Anal Chem. 2006, 78, 2450–2455. [Google Scholar] [CrossRef]
- Lobnik, A.; Turel, M.; Urek, S.K. Optical chemical sensors: Design and applications. In Advances in Chemical Sensors; Wang, W., Ed.; InTech: Rijeka, Croatia, 2012; pp. 3–28. [Google Scholar]
- Wencel, D.; Abel, T.; McDonagh, C. Optical Chemical pH Sensors. Anal. Chem. 2014, 86, 15–29. [Google Scholar] [CrossRef]
- Seitz, W.R.; Sepaniak, M.J. Chemical Sensors Based on Immobilized Indicators and Fiber Optics. CRC Crit. Rev. Anal. Chem. 1998, 19, 135–173. [Google Scholar]
- Chen, L.; Wu, L.; Yu, J.; Kuo, C.-T.; Jian, T.; Wu, I.-C.; Rong, Y.; Chiu, D.T. Highly photostable wide-dynamic-range pH sensitive semiconducting polymer dots enabled by dendronizing the near-IR emitters. Chem. Sci. 2017, 8, 7236–7245. [Google Scholar] [CrossRef] [PubMed]
- Van der Schueren, L.; de Clerck, K. Halochromic Textile Materials as Innovative pH-Sensors. Adv. Sci. Technol. 2012, 80, 47–52. [Google Scholar]
- Trovato, V.; Mezzi, A.; Brucale, M.; Abdeh, H.; Drommi, D.; Rosace, G.; Plutino, M.R. Sol-Gel Assisted Immobilization of Alizarin Red S on Polyester Fabrics for Developing Stimuli-Responsive Wearable Sensors. Polymers 2022, 14, 2788. [Google Scholar] [CrossRef]
- Colleoni, C.; Massafra, M.R.; Rosace, G. Photocatalytic properties and optical characterization of cotton fabric coated via sol–gel with non-crystalline TiO2 modified with poly(ethylene glycol). Surf. Coat. Technol. 2012, 207, 79–88. [Google Scholar] [CrossRef]
- Ielo, I.; Giacobello, F.; Castellano, A.; Sfameni, S.; Rando, G.; Plutino, M.R. Development of Antibacterial and Antifouling Innovative and Eco-Sustainable Sol–Gel Based Materials: From Marine Areas Protection to Healthcare Applications. Gels 2022, 8, 26. [Google Scholar] [CrossRef]
- Ielo, I.; Giacobello, F.; Sfameni, S.; Rando, G.; Galletta, M.; Trovato, V.; Rosace, G.; Plutino, M.R. Nanostructured Surface Finishing and Coatings: Functional Properties and Applications. Materials 2021, 14, 2733. [Google Scholar] [CrossRef] [PubMed]
- Rando, G.; Sfameni, S.; Galletta, M.; Drommi, D.; Rosace, G.; Cappello, S.; Plutino, M.R. Functional Nanohybrids and Nanocomposites development for the removal of environmental pollutants and bioremediation. Molecules 2022, 27, 4856. [Google Scholar] [CrossRef] [PubMed]
- Ielo, I.; Galletta, M.; Rando, G.; Sfameni, S.; Cardiano, P.; Sabatino, G.; Drommi, D.; Rosace, G.; Plutino, M.R. Design, synthesis and characterization of hybrid coatings suitable for geopolymeric-based supports for the restoration of cultural heritage. IOP Conf. Ser. Mater. Sci. Eng. 2020, 777, 012003. [Google Scholar] [CrossRef]
- Bhosale, R.R.; Shende, R.V.; Puszynski, J.A. Thermochemical water-splitting for H2 generation using sol-gel derived Mn-ferrite in a packed bed reactor. Int. J. Hydrogen Energy 2012, 37, 2924–2934. [Google Scholar] [CrossRef]
- Schmidt, H.; Jonschker, G.; Goedicke, S.; Mennig, M. The Sol-Gel Process as a Basic Technology for Nanoparticle-Dispersed Inorganic-Organic Composites. J. Sol-Gel Sci. Technol. 2000, 19, 39–51. [Google Scholar] [CrossRef]
- Plutino, M.; Colleoni, C.; Donelli, I.; Freddi, G.; Guido, E.; Maschi, O.; Mezzi, A.; Rosace, G. Sol-gel 3-glycidoxypropyltriethoxysilane finishing on different fabrics: The role of precursor concentration and catalyst on the textile performances and cytotoxic activity. J. Colloid Interface Sci. 2017, 506, 504–517. [Google Scholar] [CrossRef]
- Wen, J.; Wilkes, G.L. Organic/Inorganic Hybrid Network Materials by the Sol−Gel Approach. Chem. Mater. 1996, 8, 1667–1681. [Google Scholar] [CrossRef]
- Giacobello, F.; Ielo, I.; Belhamdi, H.; Plutino, M.R. Geopolymers and Functionalization Strategies for the Development of Sustainable Materials in Construction Industry and Cultural Heritage Applications: A Review. Materials 2022, 15, 1725. [Google Scholar] [CrossRef]
- Puoci, F.; Saturnino, C.; Trovato, V.; Iacopetta, D.; Piperopoulos, E.; Triolo, C.; Bonomo, M.G.; Drommi, D.; Parisi, O.I.; Milone, C.; et al. Sol–Gel Treatment of Textiles for the Entrapping of an Antioxidant/Anti-Inflammatory Molecule: Functional Coating Morphological Characterization and Drug Release Evaluation. Appl. Sci. 2020, 10, 2287. [Google Scholar] [CrossRef]
- Sanchez, C.; Julián, B.; Belleville, P.; Popall, M. Applications of hybrid organic–inorganic nanocomposites. J. Mater. Chem. 2005, 15, 3559. [Google Scholar] [CrossRef]
- Vasiljević, J.; Tomšič, B.; Jerman, I.; Simončič, B. Organofunctional Trialkoxysilane Sol-Gel Precursors for Chemical Modification of Textile Fibres. TEKSTILEC 2017, 60, 198–213. [Google Scholar] [CrossRef]
- Scurria, A.; Scolaro, C.; Sfameni, S.; Di Carlo, G.; Pagliaro, M.; Visco, A.; Ciriminna, R. Towards AquaSun practical utilization: Strong adhesion and lack of ecotoxicity of solar-driven antifouling sol-gel coating. Prog. Org. Coat. 2022, 165, 106771. [Google Scholar] [CrossRef]
- Schmidt, H. New type of non-crystalline solids between inorganic and organic materials. J. Non-Cryst. Solids 1985, 73, 681–691. [Google Scholar] [CrossRef]
- Ismail, W.N.W. Sol–gel technology for innovative fabric finishing—A Review. J. Sol-Gel Sci. Technol. 2016, 78, 698–707. [Google Scholar] [CrossRef]
- Sanchez, C.; Rozes, L.; Ribot, F.; Laberty-Robert, C.; Grosso, D.; Sassoye, C.; Boissiere, C.; Nicole, L. “Chimie douce”: A land of opportunities for the designed construction of functional inorganic and hybrid organic-inorganic nanomaterials. Comptes Rendus. Chim. 2010, 13, 3–39. [Google Scholar] [CrossRef]
- Trovato, V.; Rosace, G.; Colleoni, C.; Sfameni, S.; Migani, V.; Plutino, M.R. Sol-gel based coatings for the protection of cultural heritage textiles. IOP Conf. Ser. Mater. Sci. Eng. 2020, 777, 12007. [Google Scholar] [CrossRef]
- Rosace, G.; Cardiano, P.; Urzì, C.; De Leo, F.; Galletta, M.; Ielo, I.; Plutino, M.R. Potential roles of fluorine-containing sol-gel coatings against adhesion to control microbial biofilm. IOP Conf. Ser. Mater. Sci. Eng. 2018, 459, 12021. [Google Scholar] [CrossRef]
- Sfameni, S.; Rando, G.; Galletta, M.; Ielo, I.; Brucale, M.; De Leo, F.; Cardiano, P.; Cappello, S.; Visco, A.; Rosace, G.; et al. Design and development of fluorinated and biocide-free sol-gel based hybrid functional coatings for anti-biofouling/foul-release activity. Gels 2022, 8, 538. [Google Scholar] [CrossRef]
- De Keer, L.; Kilic, K.I.; Van Steenberge, P.H.M.; Daelemans, L.; Kodura, D.; Frisch, H.; De Clerck, K.; Reyniers, M.-F.; Barner-Kowollik, C.; Dauskardt, R.H.; et al. Computational prediction of the molecular configuration of three-dimensional network polymers. Nat. Mater. 2021, 20, 1422–1430. [Google Scholar] [CrossRef]
- Rohilla, D.; Chaudhary, S.; Umar, A. An Overview of Advanced Nanomaterials for Sensor Applications. Eng. Sci. 2021, 16, 47–70. [Google Scholar] [CrossRef]
- Widmer, S.; Dorrestijn, M.; Camerlo, A.; Urek, K.; Lobnik, A.; Housecroft, C.E.; Constable, E.C.; Scherer, L.J. Coumarin meets fluorescein: A Förster resonance energy transfer enhanced optical ammonia gas sensor. Analyst 2014, 139, 4335–4342. [Google Scholar] [CrossRef] [PubMed]
- Dunbar, A.D.F.; Brittle, S.; Richardson, T.H.; Hutchinson, J.; Hunter, C.A. Detection of Volatile Organic Compounds Using Porphyrin Derivatives. J. Phys. Chem. B 2010, 114, 11697–11702. [Google Scholar] [CrossRef] [PubMed]
- Caldara, M.; Colleoni, C.; Guido, E.; Re, V.; Rosace, G. Development of a textile-optoelectronic pH meter based on hybrid xerogel doped with Methyl Red. Sens. Actuators B Chem. 2012, 171–172, 1013–1021. [Google Scholar] [CrossRef]
- Xu, T.; Tang, Z.; Zhu, J. Synthesis of polylactide-graft-glycidyl methacrylate graft copolymer and its application as a coupling agent in polylactide/bamboo flour biocomposites. J. Appl. Polym. Sci. 2012, 125, E622–E627. [Google Scholar] [CrossRef]
- Oktay, B.; Demir, S.; Kayaman-Apohan, N. Immobilization of α-amylase onto poly(glycidyl methacrylate) grafted electrospun fibers by ATRP. Mater. Sci. Eng. C 2015, 50, 386–393. [Google Scholar] [CrossRef]
- Shukla, S.R.; Athalye, A.R. Ultraviolet radiation-induced graft copolymerization of 2-hydroxyethyl methacrylate onto polypropylene. J. Appl. Polym. Sci. 1994, 51, 1567–1574. [Google Scholar] [CrossRef]
- Vismara, E.; Bernardi, A.; Bongio, C.; Farè, S.; Pappalardo, S.; Serafini, A.; Pollegioni, L.; Rosini, E.; Torri, G. Bacterial Nanocellulose and Its Surface Modification by Glycidyl Methacrylate and Ethylene Glycol Dimethacrylate. Incorporation of Vancomycin and Ciprofloxacin. Nanomaterials 2019, 9, 1668. [Google Scholar] [CrossRef]
- Chiappone, A.; Nair, J.; Gerbaldi, C.; Zeno, E.; Bongiovanni, R. Flexible and high performing polymer electrolytes obtained by UV-induced polymer–cellulose grafting. RSC Adv. 2014, 4, 40873–40881. [Google Scholar] [CrossRef]
- Ren, Y.; Qin, Y.; Liu, X.; Huo, T.; Jiang, L.; Tian, T. Flame-retardant polyacrylonitrile fabric prepared by ultraviolet-induced grafting with glycidyl methacrylate followed by ammoniation and phosphorylation. J. Appl. Polym. Sci. 2018, 135, 4675. [Google Scholar] [CrossRef]
- Kianfar, P.; Abate, M.T.; Trovato, V.; Rosace, G.; Ferri, A.; Bongiovanni, R.; Vitale, A. Surface Functionalization of Cotton Fabrics by Photo-Grafting for pH Sensing Applications. Front. Mater. 2020, 7, 39. [Google Scholar] [CrossRef]
- Trovato, V.; Vitale, A.; Bongiovanni, R.; Ferri, A.; Rosace, G.; Plutino, M.R. Development of a Nitrazine Yellow-glycidyl methacrylate coating onto cotton fabric through thermal-induced radical polymerization reactions: A simple approach towards wearable pH sensors applications. Cellulose 2021, 28, 3847–3868. [Google Scholar] [CrossRef]
- Bamfield, P. Phenomena involving a reversible colour change. In Chromic Phenomena: The Technological Applications of Colour Chemistry; The Royal Society of Chemistry: Cambridge, UK, 2001; pp. 7–74. ISBN 0-8404-474-4. [Google Scholar]
- Guido, E.; Colleoni, C.; De Clerck, K.; Plutino, M.R.; Rosace, G. Influence of catalyst in the synthesis of a cellulose-based sensor: Kinetic study of 3-glycidoxypropyltrimethoxysilane epoxy ring opening by Lewis acid. Sens. Actuators B Chem. 2014, 203, 213–222. [Google Scholar] [CrossRef]
- Plutino, M.R.; Guido, E.; Colleoni, C.; Rosace, G. Effect of GPTMS functionalization on the improvement of the pH-sensitive methyl red photostability. Sens. Actuators B 2017, 238, 281–291. [Google Scholar] [CrossRef]
- Sfameni, S.; Rando, G.; Marchetta, A.; Scolaro, C.; Cappello, S.; Urzì, C.; Visco, A.; Plutino, M.R. Development of eco-friendly hydrophobic and fouling-release coatings for blue-growth environmental applications: Synthesis, mechanical characterization and biological activity. Gels 2022, 8, 528. [Google Scholar] [CrossRef]
- Rosace, G.; Guido, E.; Colleoni, C.; Brucale, M.; Piperopoulos, E.; Milone, C.; Plutino, M.R. Halochromic resorufin-GPTMS hybrid sol-gel: Chemical-physical properties and use as pH sensor fabric coating. Sens. Actuators B Chem 2017, 241, 85–95. [Google Scholar] [CrossRef]
- Qiu, X.; Hu, S. “Smart” Materials Based on Cellulose: A Review of the Preparations, Properties, and Applications. Materials 2013, 6, 738–781. [Google Scholar] [CrossRef]
- Van der Schueren, L.; De Clerck, K.; Brancatelli, G.; Rosace, G.; Van Damme, E.; de Vos, W. Novel cellulose and polyamide halochromic textile sensors based on the encapsulation of Methyl Red into a sol-gel matrix. Sens. Actuators B Chem 2012, 162, 27–34. [Google Scholar] [CrossRef]
- Adedayo, O.; Javadpour, S.; Taylor, C.; Anderson, W.; Moo-Young, M. Decolourization and Detoxification of Methyl Red by Aerobic Bacteria from A Wastewater Treatment Plant. World J. Microbiol. Biotechnol. 2004, 20, 545–550. [Google Scholar] [CrossRef]
- Caldara, M.; Colleoni, C.; Guido, E.; Rosace, G. Optical sensor development for smart textiles. In Proceedings of the 12th World Textile Conference AUTEX, Zadar, Croatia, 13–15 June 2012; pp. 1149–1452. [Google Scholar]
- Caldara, M.; Colleoni, C.; Guido, E.; Rosace, G.; Re, V.; Vitali, A. A wearable sensor platform to monitor sweat pH and skin temperature. In Proceedings of the IEEE International Conference on Body Sensor Networks, Cambridge, MA, USA, 6–9 May 2013; pp. 1–6. [Google Scholar]
- Caldara, M.; Colleoni, C.; Guido, E.; Re, V.; Rosace, G. Optical monitoring of sweat pH by a textile fabric wearable sensor based on covalently bonded litmus-3-glycidoxypropyltrimethoxysilane coating. Sens. Actuators B Chem 2016, 222, 213–220. [Google Scholar] [CrossRef]
- Trovato, V.; Rosace, G.; Colleoni, C.; Plutino, M.R. Synthesis and characterization of halochromic hybrid sol-gel for the development of a pH sensor fabric. IOP Conf. Ser. Mater. Sci. Eng. 2017, 254, 72027. [Google Scholar] [CrossRef]
- Trovato, V.; Colleoni, C.; Castellano, A.; Plutino, M.R. The key role of 3-glycidoxypropyltrimethoxysilane sol–gel precursor in the development of wearable sensors for health monitoring. J. Sol-Gel Sci. Technol. 2018, 87, 27–40. [Google Scholar] [CrossRef]
- Sun, X.-Z.; Branford-White, C.; Yu, Z.-W.; Zhu, L.-M. Development of universal pH sensors based on textiles. J. Sol-Gel Sci. Technol. 2015, 74, 641–649. [Google Scholar] [CrossRef]
- Barros Almeida, I.; Garcez Barretto Teixeira, L.; Oliveira de Carvalho, F.; Ramos Silva, É.; Santos Nunes, P.; Viana dos Santos, M.R.; Antunes de Souza Araújo, A. Smart Dressings for Wound Healing: A Review. Adv. Skin Wound Care 2021, 34, 1–8. [Google Scholar] [CrossRef] [PubMed]
- Khan, M.A.; Ansari, U.; Ali, M.N. Real-time wound management through integrated pH sensors: A review. Sens. Rev. 2015, 35, 183–189. [Google Scholar] [CrossRef]
- Schneider, L.A.; Korber, A.; Grabbe, S.; Dissemond, J. Influence of pH on wound-healing: A new perspective for wound-therapy? Arch. Dermatol. Res. 2007, 298, 413–420. [Google Scholar] [CrossRef]
- Schreml, S.; Szeimies, R.-M.; Karrer, S.; Heinlin, J.; Landthaler, M.; Babilas, P. The impact of the pH value on skin integrity and cutaneous wound healing. J. Eur. Acad. Dermatol. Venereol. 2010, 24, 373–378. [Google Scholar] [CrossRef]
- Cui, L.; Hu, J.; Wang, W.; Yan, C.; Guo, Y.; Tu, C. Smart pH response flexible sensor based on calcium alginate fibers incorporated with natural dye for wound healing monitoring. Cellulose 2020, 27, 6367–6381. [Google Scholar] [CrossRef]
- Hu, Q.; Huang, Q.; Liang, K.; Wang, Y.; Mao, Y.; Yin, Q.; Wang, H. An AIE+TICT activated colorimetric and ratiometric fluorescent sensor for portable, rapid, and selective detection of phosgene. Dye. Pigment. 2020, 176, 108229. [Google Scholar] [CrossRef]

| Electrochromic Polymer | Types |
|---|---|
| Electrochromic polymers based on transition metal coordination complexes | Reductive electropolymerization of polypiridyl complexes Oxidative electropolymerization of polypiridyl complexes Metallophtalocyanine electrochromic films |
| Viologen polymeric systems | Polymeric viologen systems |
| Conjugated electrochromic polymers | Pyrroles and diocypyrroles Copolymers and n-dopable electrochromic polymers Functionalized electrochromic polymers and composites Polyanilines as electrochromic materials |
| Name | R1 | R2 | R3 | X | pH Range | Color Change |
|---|---|---|---|---|---|---|
| Bromocresol Green | Br | Br | CH3 | SO2 | 3.8–5.4 | Yellow-blue |
| Bromocresol Purple | CH3 | Br | H | SO2 | 5.2–6.8 | Yellow-purple |
| Bromophenol Blue | Br | Br | H | SO2 | 3.0–4.6 | Yellow-blue |
| Bromophenol Red | Br | H | H | SO2 | 5.2–6.8 | Yellow-red |
| Bromothymol Blue | CH(CH3)2 | Br | CH3 | SO2 | 6.0–7.6 | Yellow-blue |
| Chlorophenol Red | Cl | H | H | SO2 | 4.8–6.4 | Yellow-red |
| Cresol Red | CH3 | H | H | SO2 | 7.2–8.8 | Yellow-red |
| Cresolphtalein | CH3 | H | H | CO | 8.2–9.8 | Colorless-red |
| Phenol Red | H | H | H | SO2 | 6.8–8.4 | Yellow-red |
| Phenolphtalein | H | H | H | CO | 8.5–9.0 | Colorless-red |
| Thymol Blue | CH(CH3)2 | H | CH3 | SO2 | 1.2–2.8 8.0–9.6 | Red-yellow Yellow-blue |
| Thymolphtalein | CH(CH3)2 | H | CH3 | CO | 9.3–10.5 | Colorless-blue |
| Xylenol Blue | CH3 | H | CH3 | SO2 | 1.2–2.8 8.0–9.6 | Red-yellow Yellow-blue |
| R4 | R5 | |||||
| Methyl Orange | H | SO3H | 3.1 4.4 | Red Yellow | ||
| Methyl Red | CO2H | H | 4.4 6.2 | Red Yellow |
| Types |
|---|
| Chromogenic anion sensors and metallochromism |
| Metallochromism in chelates and crown ethers |
| Fluorans |
| Leuco di- and tri-arymethanes |
| Phtalides |
| Azo and styryl dyes |
| Smart Material | Characteristics | Applications | Refs. |
|---|---|---|---|
| Chromogenic | Reversible, reusable, solid-state applications, stimuli-responsive, color-change detection to the naked eye | Eye patch biosensors for biomarkers in human tears, glucose monitoring, sweat monitoring | [169,170,171] |
| Photochromic | Color-changing capacity when exposed to light and sunlight (IR and UV radiations) can alter their optical characteristics; high temperatures can accelerate the material decomposition | Fluorimetric multi-sensing of sweat biomarkers, UV indicators, temperature, and sweat pH sensing | [172,173,174] |
| Thermochromic | Different color states at different temperatures, versatile | Human movement monitoring (strain), body temperature | [175,176,177] |
| Electrochromic | Sensitive to redox reactions, they have to feature a fast response to injection and ejection processes, coloration efficiency, high contrast level, specified life cycle, and write–erase efficiency | Skin temperature and wrist movement, alarm system for smart contact lenses, glucose sensing | [178,179,180] |
| Ionochromic | Color-changing ability by inducing ionic species in an ionic state, versatile, selective, different commercial applications | pH monitoring, acid gas sensing, ammonia gas detection | [181,182] |
| Mechanochromic | Optical-changing properties when subjected to mechanical stimuli, low pressure-responsive ability, versatile | Volatile organic compound (VOC) detection, subtle and large human motion sensing | [183,184] |
| Solvatochromic | Display different colors depending on the solvent in which they are dissolved, versatile, highly sensitive | Lactate sensing, sweat analysis | [185,186] |
| Biochromic | Changes color through biochemical or hydrolysis reactions upon exposure to a biological stimulus, can be exploited for various biological potential applications | Sweat sensing, glucose detection, in vitro perspiration monitoring | [187,188,189] |
| Sample | Performance |
|---|---|
| CO conventionally dyed | 1 |
| CO sol–gel dyed | 4 |
| PA conventionally dyed | 2/3 |
| PA sol–gel dyed | 5 |
Publisher’s Note: MDPI stays neutral with regard to jurisdictional claims in published maps and institutional affiliations. |
© 2022 by the authors. Licensee MDPI, Basel, Switzerland. This article is an open access article distributed under the terms and conditions of the Creative Commons Attribution (CC BY) license (https://creativecommons.org/licenses/by/4.0/).
Share and Cite
Trovato, V.; Sfameni, S.; Rando, G.; Rosace, G.; Libertino, S.; Ferri, A.; Plutino, M.R. A Review of Stimuli-Responsive Smart Materials for Wearable Technology in Healthcare: Retrospective, Perspective, and Prospective. Molecules 2022, 27, 5709. https://doi.org/10.3390/molecules27175709
Trovato V, Sfameni S, Rando G, Rosace G, Libertino S, Ferri A, Plutino MR. A Review of Stimuli-Responsive Smart Materials for Wearable Technology in Healthcare: Retrospective, Perspective, and Prospective. Molecules. 2022; 27(17):5709. https://doi.org/10.3390/molecules27175709
Chicago/Turabian StyleTrovato, Valentina, Silvia Sfameni, Giulia Rando, Giuseppe Rosace, Sebania Libertino, Ada Ferri, and Maria Rosaria Plutino. 2022. "A Review of Stimuli-Responsive Smart Materials for Wearable Technology in Healthcare: Retrospective, Perspective, and Prospective" Molecules 27, no. 17: 5709. https://doi.org/10.3390/molecules27175709
APA StyleTrovato, V., Sfameni, S., Rando, G., Rosace, G., Libertino, S., Ferri, A., & Plutino, M. R. (2022). A Review of Stimuli-Responsive Smart Materials for Wearable Technology in Healthcare: Retrospective, Perspective, and Prospective. Molecules, 27(17), 5709. https://doi.org/10.3390/molecules27175709






